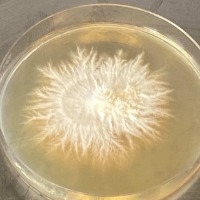

Flytande mycel VS sporspruta?
Isolerad genetik - stort genetiskt innehåll
Flytande mycel består av aktivt levande mycel som är redo att kolonisera ett substrat. Det innebär snabbare tillväxt, jämnare resultat och mindre osäkerhet jämfört med odling från sporer.
Den största fördelen med flytande mycel är att kulturen vanligtvis kommer från en isolerad stam eller klon. Det betyder att mycelet har valts ut för specifika egenskaper, till exempel snabb kolonisering, stabil fruktsättning och bra avkastning. Resultatet blir därför mer förutsägbart när du odlar.
Det finns även flytande kulturer som inte är isolerade, utan är odlade direkt från sporer, en så kallad " multispore LC ". Dessa innehåller fortfarande ett brett genetiskt spektrum, vilket innebär att tillväxt, koloniseringstid och avkastning kan variera mellan olika inokuleringar. Fördelen är att de kan ge möjlighet att upptäcka starka fenotyper och fungerar bra för vidare selektionsarbete. Nackdelen är att resultatet blir mindre förutsägbart jämfört med en isolerad flytande mycelkultur.
En sporspruta innehåller precis som multispore LC, stor genetisk variation och när sporerna gror kan många olika genetiska kombinationer uppstå. Detta är en stor fördel i naturen eftersom svampen får bättre chans att anpassa sig till olika miljöer. För odling kan det däremot innebära att resultatet varierar kraftigt mellan olika odlingar.
Det är dock viktigt att nämna att sporer har en viktig roll inom svampodling. De används ofta för att ta fram ny genetik och för selektion av nya stammar. För den som vill experimentera eller utveckla egna isolat är sporer ett värdefullt verktyg. För de flesta odlare som vill ha stabila och reproducerbara resultat är flytande mycel däremot det mest praktiska valet.
Flytande mycel är därför ett betydligt enklare alternativ för odlare som vill ha snabb och pålitlig kolonisering. Mycelet i sprutan är redan selekterat och redo att användas direkt för att skapa grain spawn eller inokulera substrat.